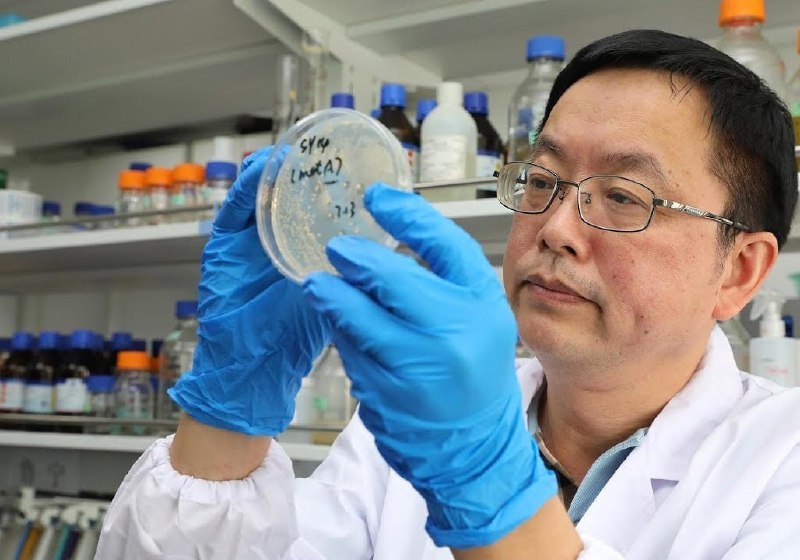

Китай выразил беспокойство в связи с незаконным вывозом биологических материалов за пределы страны.⚠️
По мнению служб безопасности КНР (https://www.globaltimes.cn/page/202601/1354262.shtml), иностранные компании могут использовать совместные проекты как предлог для получения биологических образцов от китайских организаций с последующим тайным вывозом этих материалов за границу.🔍
▪️Стоит отметить, что на протяжении всей пандемии Китай принудительно собирал биообразцы у всех иностранных граждан, приезжавших в страну.🧬
. Китай. Новости (https://t.me/chinakzz)📰
#Китай #биообразцы #безопасность #закон #пандемия #экспорт #международныеотношения🌏
Китайская жизнь https://t.me/chinakzz
Allesasia.com – Ваш помощник в бизнесе с Китаем
Источник: https://t.me/chinakzz/2998